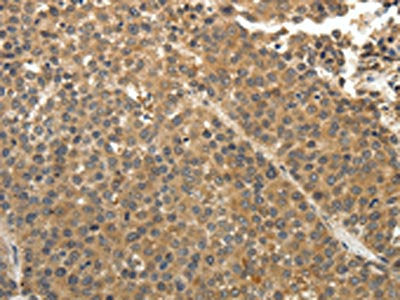
The image on the left is immunohistochemistry of paraffin-embedded Human liver cancer tissue using CSB-PA071225(EIF2AK3 Antibody) at dilution 1/30, on the right is treated with fusion protein. (Original magnification: ×200)

Product Overview
Product Overview
Alternative names
DKFZp781H1925 antibody; E2AK3_HUMAN antibody; EC 2.7.11.1 antibody; Eif2ak3 antibody; Eukaryotic translation initiation factor 2 alpha kinase 3 antibody; Eukaryotic translation initiation factor 2-alpha kinase 3 antibody; Heme regulated EIF2 alpha kinase antibody; HRI antibody; HsPEK antibody; Pancreatic eIF2 alpha kinase antibody; Pancreatic eIF2-alpha kinase antibody; PEK antibody; PRKR like endoplasmic reticulum kinase antibody; PRKR-like endoplasmic reticulum kinase antibody; WRS antibody
Antigen
Fusion protein of Human EIF2AK3
Buffer
pH7.4 of PBS, 0.05% NaN3, 40% Glycerol.
Clonality
Polyclonal
Clone number
N/A
Conjugated
Non-conjugated
Form
Liquid
Host species
Rabbit
Isotype
IgG
Purification method
Antigen Affinity Purified
Research area
Epigenetics and Nuclear Signaling
Species
Human
Species reactivity
Human, Mouse, Rat
Storage
Upon receipt, store at -20°C or -80°C. Avoid repeated freeze.
Target name
EIF2AK3
Tested applications
ELISA, IHC; ELISA:1:1000-1:5000, IHC:1:25-1:100
Uniprot id
Q9NZJ5
Documents
Documents
Background
Background
Target: EIF2AK3. Antigen: Fusion protein of Human EIF2AK3. Reactivity: Human, Mouse, Rat. Applications: ELISA, IHC; ELISA:1:1000-1:5000, IHC:1:25-1:100. Polyclonal IgG Clone N/A.
Product Citations
Product Citations
More Info
More Info
EIF2AK3 Antibody
EIF2AK3 Antibody
Regular price
$166.00 USD
Sale price
$166.00 USD
Regular price
Unit price
/per
Shipping calculated at checkout.
Available in stock (500)
Request a Quote
✅ Thank you! Your quote request was sent successfully.
❌ Something went wrong. Please check your details and try again.
- Customs clearance fees may apply
- Worldwide shipping available.
Couldn't load pickup availability
For research use only — not intended for clinical or diagnostic purposes.
Product Overview
Product Overview
Alternative names
DKFZp781H1925 antibody; E2AK3_HUMAN antibody; EC 2.7.11.1 antibody; Eif2ak3 antibody; Eukaryotic translation initiation factor 2 alpha kinase 3 antibody; Eukaryotic translation initiation factor 2-alpha kinase 3 antibody; Heme regulated EIF2 alpha kinase antibody; HRI antibody; HsPEK antibody; Pancreatic eIF2 alpha kinase antibody; Pancreatic eIF2-alpha kinase antibody; PEK antibody; PRKR like endoplasmic reticulum kinase antibody; PRKR-like endoplasmic reticulum kinase antibody; WRS antibody
Antigen
Fusion protein of Human EIF2AK3
Buffer
pH7.4 of PBS, 0.05% NaN3, 40% Glycerol.
Clonality
Polyclonal
Clone number
N/A
Conjugated
Non-conjugated
Form
Liquid
Host species
Rabbit
Isotype
IgG
Purification method
Antigen Affinity Purified
Research area
Epigenetics and Nuclear Signaling
Species
Human
Species reactivity
Human, Mouse, Rat
Storage
Upon receipt, store at -20°C or -80°C. Avoid repeated freeze.
Target name
EIF2AK3
Tested applications
ELISA, IHC; ELISA:1:1000-1:5000, IHC:1:25-1:100
Uniprot id
Q9NZJ5
Documents
Documents
Background
Background
Target: EIF2AK3. Antigen: Fusion protein of Human EIF2AK3. Reactivity: Human, Mouse, Rat. Applications: ELISA, IHC; ELISA:1:1000-1:5000, IHC:1:25-1:100. Polyclonal IgG Clone N/A.
Product Citations
Product Citations
More Info
More Info

EIF2AK3 Antibody
Regular price
$166.00 USD
Sale price
$166.00 USD
Regular price
Unit price
/per